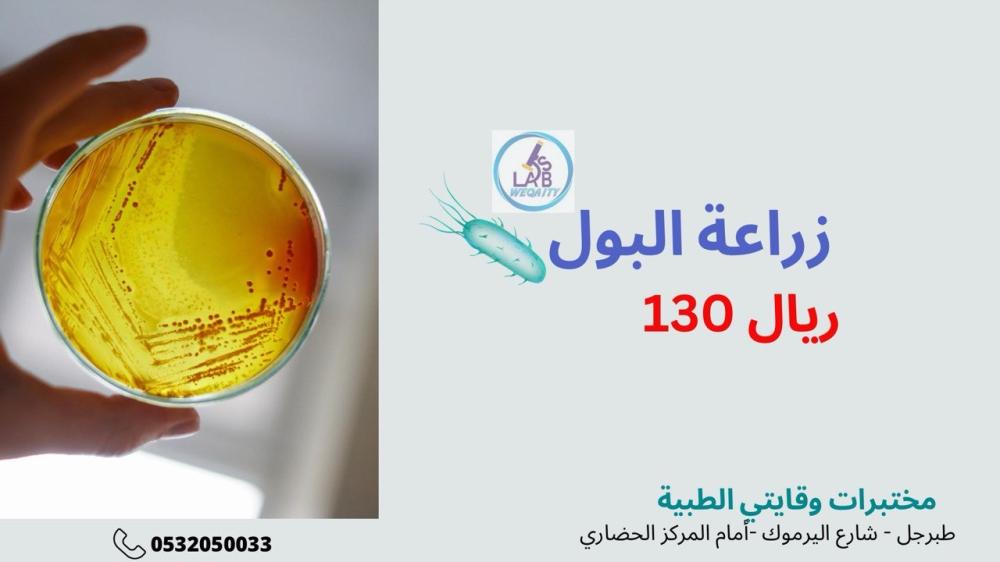

- الرئيسية
- زراعة البول
زراعة البول
130 ر.س
غير متوفر حالياً
إنطلاقا من قلب رسالتنا المتمحورة حول توفير خدمات عالية الجودة نقدم مجموعة واسعة من الفحوصات الطبية المختلفه التي تستخدم في التشخيص الطبي... أنشأت مختبرات وقايتي الطبية في منطقة الجوف - محافظة طبرجل